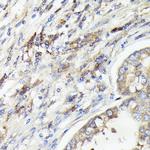
IL-1 alpha Antibody in Immunohistochemistry (Paraffin) (IHC (P))

Search
Invitrogen
IL-1 alpha Polyclonal Antibody
{{$productOrderCtrl.translations['antibody.pdp.commerceCard.promotion.promotions']}}
{{$productOrderCtrl.translations['antibody.pdp.commerceCard.promotion.viewpromo']}}
{{$productOrderCtrl.translations['antibody.pdp.commerceCard.promotion.promocode']}}: {{promo.promoCode}} {{promo.promoTitle}} {{promo.promoDescription}}. {{$productOrderCtrl.translations['antibody.pdp.commerceCard.promotion.learnmore']}}
图: 1 / 4
IL-1 alpha Antibody (PA5-89037) in IHC (P)

Please note: We are reviewing Western blot images included in the antibody testing data in our catalog, including those provided by third parties. Unless expressly labeled or annotated as “raw-unedited”, Western blot images included in the antibody testing data in our catalog may have been edited, optimized or otherwise adjusted for presentation.
产品信息
PA5-89037
种属反应
已发表种属
宿主/亚型
分类
类型
抗原
偶联物
形式
浓度
规格
纯化类型
保存液
内含物
保存条件
运输条件
RRID
产品详细信息
Immunogen sequence: SAPFSFLSNV KYNFMRIIKY EFILNDALNQ SIIRANDQYL TAAALHNLDE AVKFDMGAYK SSKDDAKITV ILRISKTQLY VTAQDEDQPV LLKEMPEIPK TITGSETNLL FFWETHGTKN YFTSVAHPNL FIATKQDYWV CLAGGPPSIT DFQIL
Positive Samples: NCI-H460, SKOV3
靶标信息
IL-1 alpha (Interleukin-1 alpha) is a proinflammatory cytokine expressed by monocytes, macrophages, and dendritic cells. IL-1 alpha is coded by the IL1A gene and signals through two receptors, IL-1RI and IL-1RII, both of which are shared with IL-1 beta. IL1A is located on the q arm on chromosome 2 at position 13. IL-1 alpha plays an important role in innate host defense by triggering the production of other proinflammatory cytokines in target cells and initiating acute-phase responses. IL-1 alpha activity can be moderated by IL-1 Receptor Antagonist (IL-1RA), a protein produced by many cell types that blocks receptor binding through competitive inhibition. IL-1 alpha is a pleiotropic cytokine involved in various immune responses, inflammatory processes, and hematopoiesis. Further, IL-1 alpha is produced by monocytes and macrophages as a proprotein, which is proteolytically processed and released in response to cell injury and induces apoptosis. The IL1A gene and eight other interleukin 1 family genes form a cytokine gene cluster on chromosome 2. IL1 alpha regulates the activities of NF-kappaB and mitogen-activated protein kinases. IL-1 alpha can stimulate the expression of IL6 and cyclooxygenase-2 (PTGS2/COX-2), as well as enhance the production of nitric oxide (NO). High levels of IL-1 alpha are associated with several chronic inflammatory diseases including rheumatoid arthritis, psoriasis and multiple sclerosis.
仅用于科研。不用于诊断过程。未经明确授权不得转售。
生物信息学
蛋白别名: CTLA8; Hematopoietin-1; IL 1 a; IL 1α; IL-1 alpha; IL17; IL1A; IL1α; ILN; Interleukin; interleukin 17; Interleukin-1 alpha; Interleukin-17A; Interleukin1 alpha; preinterleukin 1 alpha; pro-interleukin-1-alpha; RP23-160G19.8; unnamed protein product
基因别名: IL-1 alpha; IL-1A; IL1; IL1-ALPHA; IL1A; IL1F1
UniProt ID: (Mouse) P01582, (Rat) P16598
Entrez Gene ID: (Human) 3552, (Mouse) 16175, (Rat) 24493




